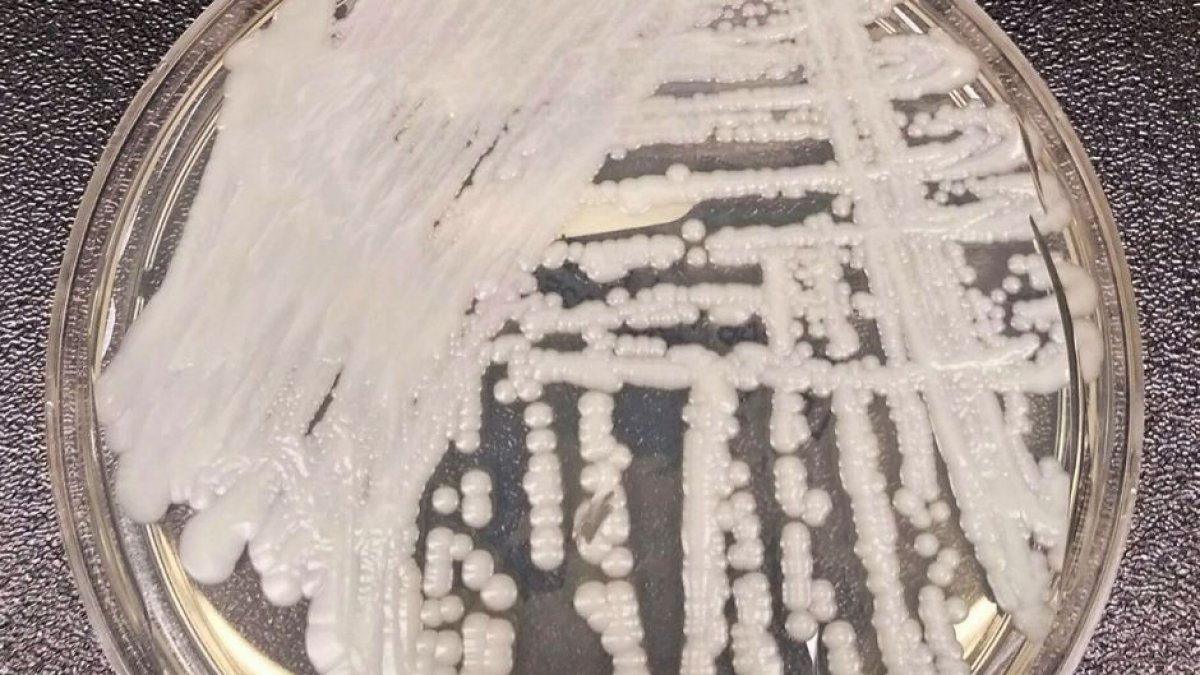
(Wikimedia Commons)

Candida auris, the new "urgent threat" to the United States
The fungus mainly affects people with previous illnesses and can be "potentially lethal."
(Wikimedia Commons)
A fungus is spreading throughout the United States. Its name is Candida auris and it is considered to be an "urgent threat" to the country. According to the journal Annals of Internal Medicine, cases have been increasing year after year and nearly doubled from 2019-2021:
Candida auris first appeared in the United States in 2016. Initially, most cases were concentrated in New York and Chicago, but it is now present in nearly half of the nation's states, with 17 states reporting at least one case of Candida auris in recent years.
"Potentially lethal" for sick people
The infection does not affect healthy people. However, the Centers for Disease Control and Prevention (CDC) warned that the fungus is drug-resistant and can be "potentially lethal" for the population with previous pathologies. In these individuals, as well as those who have invasive medical devices or spend long periods of time in healthcare facilities, a Candida auris infection could cause serious illness and even death.
Dr. Meghan Lyman, the study's lead author and public health agency epidemiologist, said in a press release that the spread may be due to "pandemic-related pressure on medical care and the public health system":